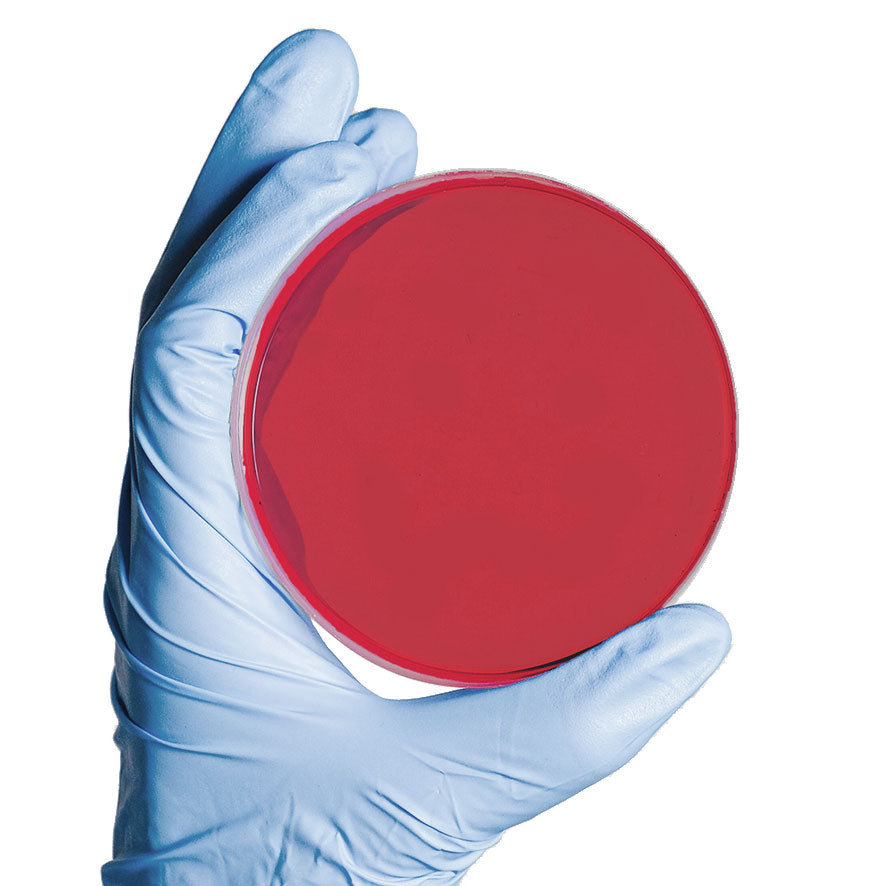
Mannit-Kochsalz-Agar - 20 Stk.

Kostenloser Versand
ab 200€ Netto-Warenwert
(innerhalb Deutschlands)
Kompetente und persönliche Fachberatung
durch unsere erfahrenen
AUROSAN-Mitarbeiter
Technik & Digitales
Umfassende Prüfung,
Wartung und Reparatur,
inkl. Softwareanbindung
Zertifizierte Qualität
über 5000 hochwertige Medizinprodukte von führenden Markenherstellern
Preise & Konditionen
mit vielen Tagespreisen und Staffeln für Abnahme größerer Mengen
Sichere Zahlung
und einfache, schnelle Auftragsbearbeitung